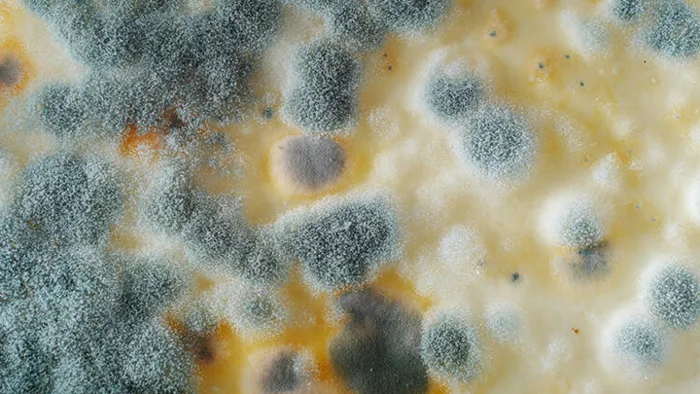
bu-gidalari-sakin-tuketmeyin-bir-sey-olmaz-deyip-tuketenler-bin-pisman-tek-bir-isirigi-bile-1702287969242.jpg

Bu gıdaları sakın tüketmeyin! Bir şey olmaz deyip tüketenler bin pişman! Tek bir ısırığı bile...
Küflü yiyeceklerin sağlığımız üzerindeki etkileri çoğu zaman göz ardı ediliyor. Ancak bu yiyeceklerin vücudumuz üzerinde bazı ciddi sonuçlar doğurabileceği bir gerçek. Bu noktada sizlerle bilinmesi gereken tüm bilgileri paylaşıyoruz. İşte küflü yiyeceklerin sağlığınıza etkileri ve dikkat etmeniz gerekenler!

Küflü yiyeceklerde bulunan toksinler, karaciğer hasarına yol açabilir. Özellikle yer fıstığı ve mısır gibi bazı yiyeceklerde bulunan aflotoksinler, karaciğer üzerinde ciddi etkilere sahiptir. Bu toksik maddeler, kusma, mide bulantısı ve ishal gibi belirtilere neden olabilir. Bağışıklık sisteminizin gücü, bu etkilerin şiddetini belirleyebilir. Ancak unutmayın tüm küflü yiyecekler bu tehlikeyi barındırmaz.

GIDA ZEHİRLENMESİNE NEDEN OLUYOR
Küflü yiyecekler, gıda zehirlenmesine yol açabilecek bakteriler içerebilir. Özellikle küflü ekmek gibi ürünler, kusma ve ishal gibi zehirlenme belirtilerine neden olabilir. Bu durum, tükettiğiniz yiyeceğin bakteri türü ve miktarına bağlı olarak değişkenlik gösterir.

Küf Alerjisi ve Belirtileri
Bazı bireyler, küflü yiyeceklerde bulunan alerjenlere karşı hassas olabilir. Eğer küfe karşı bir alerjiniz varsa, bu yiyeceklerden uzak durmalısınız. Yanlışlıkla tükettiğinizde ise derhal doktorunuza başvurmalısınız. Alerjik reaksiyonlar, kaşıntılı ve sulu gözler, kurdeşen, kızarıklık, hırıltı, burun akıntısı veya tıkanıklık şeklinde kendini gösterebilir.